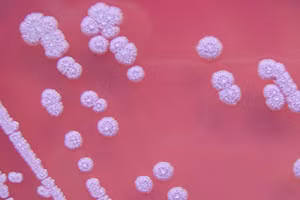
Vi khuẩn Burkholderia Pseudomalle. Ảnh: VTV

Tiếp nhận nhiều ca bệnh mắc Whitmore
GD&TĐ - Bệnh viện Bạch Mai tiếp nhận nhiều ca mắc Whitmore với triệu chứng sốt, kém ăn, sụt cân, sưng, áp xe một số vị trí trên cơ thể.

GD&TĐ - Bệnh viện Bạch Mai tiếp nhận nhiều ca mắc Whitmore với triệu chứng sốt, kém ăn, sụt cân, sưng, áp xe một số vị trí trên cơ thể.

GD&TĐ - Bệnh viện Đa khoa tỉnh Hòa Bình cho biết đang điều trị 2 bệnh nhân bị suy đa tạng, nguy kịch do mắc Whitmore (vi khuẩn ăn thịt người).